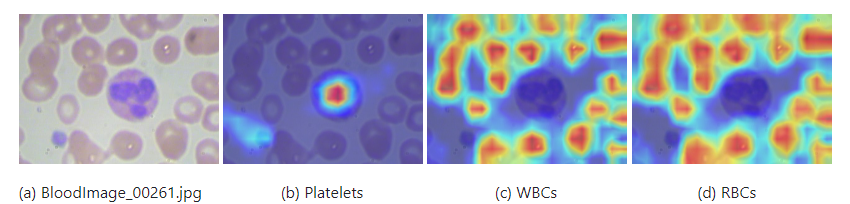
DL00354-改进型YOLOv7血细胞检测分类加入Swin transformer

sWin 相关推荐
sWin 优惠券折扣
商品筛选
-
 玩具/童车/益智/积木/模型
45
低价
玩具/童车/益智/积木/模型
45
低价
Swin内管官方内管平口倒角NERF前管精拉管适配雨燕预言G2工匠女神
销量60 志气软软堂
购买 -
 玩具/童车/益智/积木/模型
60
低价
玩具/童车/益智/积木/模型
60
低价
一休定制老孙家SWIN快锁螺纹管ESAYLOCK镜面精准内管软蛋玩具配件
销量27 一休哥军迷潮玩发射器
购买 -
 箱包皮具/热销女包/男包
25930
单品直降
箱包皮具/热销女包/男包
25930
单品直降
306031h可退 香港直邮Brunello Cucinelli 布内罗·古奇拉利 女士 Swin
天猫好物 天猫国际探物之选
优惠1000元 -
 女装/女士精品
77.4
官方立减
女装/女士精品
77.4
官方立减
88美人百花揭晓 日本原单 swin*** gle 精致 蕾丝无 袖衬衫
淘宝好物 日本精品女装
优惠10.6元 -
商务/设计服务
998
低价
商务/设计服务
998
低价
DL00354-改进型YOLOv7血细胞检测分类加入Swin transformer
淘宝好物 猛犸AI科技
购买 -
 商务/设计服务
2976
低价
商务/设计服务
2976
低价
DL00233-轴承故障诊断python基于小波时频图与Swin Transformer
淘宝好物 猛犸AI科技
购买 -
 商务/设计服务
2869
低价
商务/设计服务
2869
低价
DL00319-基于swin transformer的眼疾病检测含数据集完整
淘宝好物 猛犸AI科技
购买 -
 金属材料及制品
65.1
低价
金属材料及制品
65.1
低价
Barbie pink plaid skirt with a cute waistband and large swin
淘宝好物 东荒的鑫杰的小店
购买 -
 运动包/户外包/配件
19.4
低价
运动包/户外包/配件
19.4
低价
Japans anime spell back to the war Gojo Goh white hair swin
淘宝好物 T198 Flagship Store
购买 -
 办公设备/耗材/相关服务
157.02
低价
办公设备/耗材/相关服务
157.02
低价
ARRMA 1 5 KRATON OUTCAST Katun Rangers 5*96mm Universal Swin
淘宝好物 tb980 flagship store
购买 -
 玩具/童车/益智/积木/模型
155
折扣
玩具/童车/益智/积木/模型
155
折扣
18一休定制SWIN可调金属鱼线管快锁二代可换高中低内芯海绵软蛋玩具
销量18 一休哥军迷潮玩发射器
购买 -
 玩具/童车/益智/积木/模型
45
折扣
玩具/童车/益智/积木/模型
45
折扣
4570一休定制swin阿尔法海绵软弹发射器玩具T0精准吃鸡玩具枪
销量1 一休哥军迷潮玩发射器
购买 -
 全新电芯稳定耐用不伤机 质保1年只换不修
116
券后价
全新电芯稳定耐用不伤机 质保1年只换不修
116
券后价
138适用于机械革命 S2 S1pro-01 02 MX350 SSBS73 SWIN-GGRTTF01 笔记本电脑电池
销量55 硕之宝旗舰店
5元优惠券 -
 运动/瑜伽/健身/球迷用品
279
单品直降
运动/瑜伽/健身/球迷用品
279
单品直降
442日本直邮TEAM SERIZAWA×Tabata Golf 共同开发 TS Complete Swin
天猫好物 天猫国际探物日本
优惠109元 -
 3C数码配件
13.8
券后价
3C数码配件
13.8
券后价
16.9适用Garmin佳明运动手表充电器FENIX系列飞耐时945/245充电线instinct本能swin2快充Active数据线usb通PRO
销量6 锋卓旗舰店
1元优惠券 -
 商务/设计服务
100
低价
商务/设计服务
100
低价
图像分割代做pytorch代码Unet定制优化Swin算法调试模型SegFormer
销量3 览平科技工作室
购买 -
 运动服/休闲服装
311
官方立减
运动服/休闲服装
311
官方立减
366日本直邮Columbia Swin Avenue Omni Freeze Xerographic 短袖T恤
天猫好物 Rakuten Life海外旗舰店
优惠55元 -
 运动服/休闲服装
249
官方立减
运动服/休闲服装
249
官方立减
293日本直邮Columbia SWIN AVENUE OFZ GRAPHIC S/S TEE PM0703 男士
天猫好物 Rakuten Life海外旗舰店
优惠44元 -
 电子元器件市场
45.68
券后价
电子元器件市场
45.68
券后价
52.684pc Propeller Prop CW CCW for Parrot Minidrones 3 Mambo Swin
淘宝好物 Trading company
7元优惠券 -
 户外/登山/野营/旅行用品
95.96
官方立减
户外/登山/野营/旅行用品
95.96
官方立减
109.96Golf Swing Practice Telescopic Golf Swing Trainer Golf Swin
淘宝好物 金豪城168精品
优惠14元 -
 女装/女士精品
121
官方立减
女装/女士精品
121
官方立减
138日本原单 Swin**gle七分袖撞色连衣裙
淘宝好物 日本精品女装
优惠17元 -
 运动服/休闲服装
228
官方立减
运动服/休闲服装
228
官方立减
260日本直邮Columbia Swin Avenue Omni Freeze Xerographic 短袖T恤
天猫好物 天猫国际全球探物
优惠32元 -
 运动服/休闲服装
228
官方立减
运动服/休闲服装
228
官方立减
260日本直邮Columbia Swin Avenue Omni Freeze Xerographic 短袖T恤
天猫好物 天猫国际探物日本
优惠32元 -
 运动服/休闲服装
350
单品直降
运动服/休闲服装
350
单品直降
399日本直邮Columbia-2025春季/夏季哥伦比亚男士户外短袖T恤T恤Swin
天猫好物 天猫国际探物日本
优惠1元 -
 运动服/休闲服装
350
单品直降
运动服/休闲服装
350
单品直降
399日本直邮Columbia-2025春季/夏季哥伦比亚男士户外短袖T恤T恤Swin
天猫好物 天猫国际全球探物
优惠1元 -
 运动服/休闲服装
186
官方立减
运动服/休闲服装
186
官方立减
212日本直邮Columbia SWIN AVENUE OFZ GRAPHIC S/S TEE PM0703 男士
天猫好物 天猫国际全球探物
优惠26元 -
 运动服/休闲服装
186
官方立减
运动服/休闲服装
186
官方立减
212日本直邮Columbia SWIN AVENUE OFZ GRAPHIC S/S TEE PM0703 男士
天猫好物 天猫国际探物日本
优惠26元 -
 运动/瑜伽/健身/球迷用品
280
官方立减
运动/瑜伽/健身/球迷用品
280
官方立减
319日本直邮TEAM SERIZAWA×Tabata Golf 共同开发 TS Complete Swin
天猫好物 天猫国际全球探物
优惠39元 -
 箱包皮具/热销女包/男包
42753
单品直降
箱包皮具/热销女包/男包
42753
单品直降
48697欧洲直邮BV葆蝶家 25秋冬 795074V2HL12364 男士 单肩包 小号Swin
天猫好物 天猫国际探物欧洲
优惠100元 -
 箱包皮具/热销女包/男包
42755
单品直降
箱包皮具/热销女包/男包
42755
单品直降
48699欧洲直邮BV葆蝶家 25秋冬 795074V2HL12364 男士 单肩包 小号Swin
天猫好物 天猫国际全球探物
优惠100元